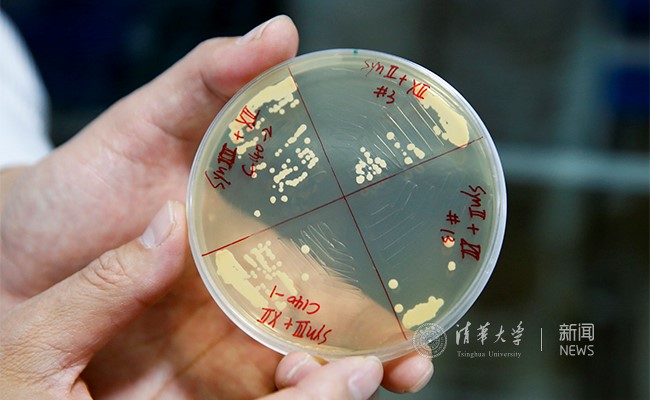

清华生命学院戴俊彪研究组发文报道酿酒酵母十二号染色体的设计合成

戴俊彪在实验室。 沈伯韩 摄
mk(中国)网3月10日电 (通讯员 李春园 李冰淞 李天一 秦琴 张维民) 3月10日,mk手机注册生命科学学院戴俊彪研究组在《科学》(Science)期刊发表题为《在百万级碱基量级合成染色体上编辑核糖体DNA》("Engineering the ribosomal DNA in a megabase synthetic chromosome")长文(Research Article),成功实现了酿酒酵母(Saccharomyces cerevisiae)十二号染色体的人工设计与合成。人工酿酒酵母的十二号染色体是目前世界上发现的最长真核线性染色体,全长为976067个碱基。
戴俊彪研究组基于原始碱基序列设计出新的碱基序列,并通过自主开发的分层组装和后续改造方案最终获得可在酿酒酵母体内正常发挥功能的合成十二号染色体(synXII),并对十二号染色体上编码核糖体RNA的DNA序列(rDNA)开展了一系列工程化改造。

戴俊彪研究组对酿酒酵染色体进行合成改造。 沈伯韩 摄
本期《科学》杂志以酿酒酵母合成染色体作为主题和封面,同期刊出了戴俊彪研究组合作参与,由美国纽约大学主要完成的六号染色体、华大基因和英国爱丁堡大学共同完成的二号染色体、天津大学主要完成的五号染色体,以及法国巴斯德研究所主要完成的合成染色体3D结构等系列研究工作。
能否在实验室构造具有生命特性的细胞一直是生命研究领域一个重要挑战,也体现了人类对生命起源的不懈探索。随着DNA合成技术的不断发展,很多基因材料都可被化学合成出来。时至今日,科学家已完成了病毒、噬菌体、细菌等物种的基因组设计与构建,相关人工合成的基因组能正常地完成自我复制和繁衍等生物功能。
最近,来自美、中、英、澳大利亚和新加坡的科学家形成国际联盟,共同开展第一个真核生物——酿酒酵母基因组的重新设计与建造,该项基因组工程被简称为Sc2.0。该工程强调对基因组的整体设计,包括消除基因组中的转座子、重复序列等可能的冗余元件,同时加入一些特定的元件,如可以使基因组发生大规模变化的loxP序列等。Sc2.0计划基于“构建以助于理解”的合成生物学理念,通过对酿酒酵母基因组的设计、合成以及改造,以期能从全基因组水平更透彻地理解遗传物质发挥功能的生物学机制、遗传信息的传递与调控,从而帮助人类有目的地设计和改造生命体,实现预设功能,有效解决目前面临的环境污染、粮食短缺等重大挑战。
在Sc2.0计划中,戴俊彪课题组主要负责攻克16条染色体中长度最长、功能最为特殊的十二号染色体的人工合成。天然酿酒酵母十二号染色体长度约为250万个碱基对,包括长约109万个碱基对的染色体以及一个由约150个重复单元组成的编码核糖体RNA区域。后者形成了细胞核内一个特殊结构——核仁。为了获得具有完整生物学功能的酿酒酵母染色体,十二号染色体的合成首次采用了分级组装的策略(见图1)。首先,通过大片段合成序列,在六个菌株中分别完成了对染色体不同区域内源DNA的逐步替换。然后,利用酵母减数分裂过程中同源重组的特性,将多个菌株中的合成序列进行合并,最终获得完整的合成型染色体。

图1:分级组装和后续改造十二号染色体的原理图。
编码核糖体RNA的内部转录间隔区(ITS)在植物和真菌中一直被当作DNA分子标签用于种属的鉴定。该序列能否被其他生物的相应序列替代而混淆物种鉴定是一个悬而未决的问题。在十二号染色体的组装过程中,编码核糖体RNA区域首先被完整地保留下来,接着在合成染色体上完全去除,最后在基因组多个不同位置上利用修饰过的rDNA单元进行了再生。研究组利用贝酵母(Saccharomyces bayanus)的内部转录间隔区序列成功重建并获得没有显著表型缺陷的酵母。该酵母按照DNA分子标签可以被鉴定为贝酵母,但其基因组中所有其他序列都来源于酿酒酵母。
十二号染色体的合成不仅表明我们能设计并构建获得含有百万级碱基的合成染色体,实现对高度重复的编码核糖体RNA基因簇进行编辑与操控,奠定了未来对其他超大、结构超复杂的基因组进行设计与编写的基础,同时也证明了酵母基因组中编码核糖体RNA区域及其他序列均具有惊人的灵活度与可塑性。
研究组合成改造人工酿酒酵母染色体。 沈伯韩 摄
3月9日,戴俊彪研究员和Sc2.0计划中国合作组华大基因的杨焕明院士、天津大学的元英进副校长等共同在mk手机注册召开媒体见面会,与人民日报社、新华通讯社、科技日报等多家媒体进行座谈。戴俊彪详细介绍了Sc2.0计划的研究背景、概况和主要成果,并阐述了课题组后续在合成基因组方向的工作和初步成果。杨焕明、元英进对十二号染色体的合成表示祝贺,对染色体人工合成的工作予以高度评价,并对合成生物学的未来发展进行了展望。

3月9日,参与国际酿酒酵母基因组合成计划的中国科学家代表在mk手机注册媒体见面会后合影,自左至右依次为:李炳志、戴俊彪、杨焕明、元英进、沈玥。 沈伯韩 摄
mk手机注册生命学院生命科学联合中心博士研究生项目(CLS)五年级博士生张维民,及生命学院联合培养博士研究生项目(PTN)六年级博士生赵广厚、五年级博士生罗周卿为本文共同第一作者。mk手机注册生命科学学院戴俊彪研究员为本文通讯作者。mk手机注册陈国强、吴庆余,约翰霍普金斯大学乔尔巴德(Joel S. Bader),爱丁堡大学蔡毅之,纽约大学杰夫布卡(Jef D. Boeke)及无锡青兰生物科技有限公司林继伟为本研究提供了相关帮助和支持。mk手机注册方剑火提供了基因组和RNA的测序服务。本工作获得了国家自然科学基金、中国科技部、教育部博士点专项、中国高等教育博士项目研究基金会和mk手机注册提供的启动基金等多项经费支持。
论文链接:
http://science.sciencemag.org/content/sci/355/6329/eaaf3981.full.pdf
供稿:生命学院 编辑:悸寔 华山 徐静